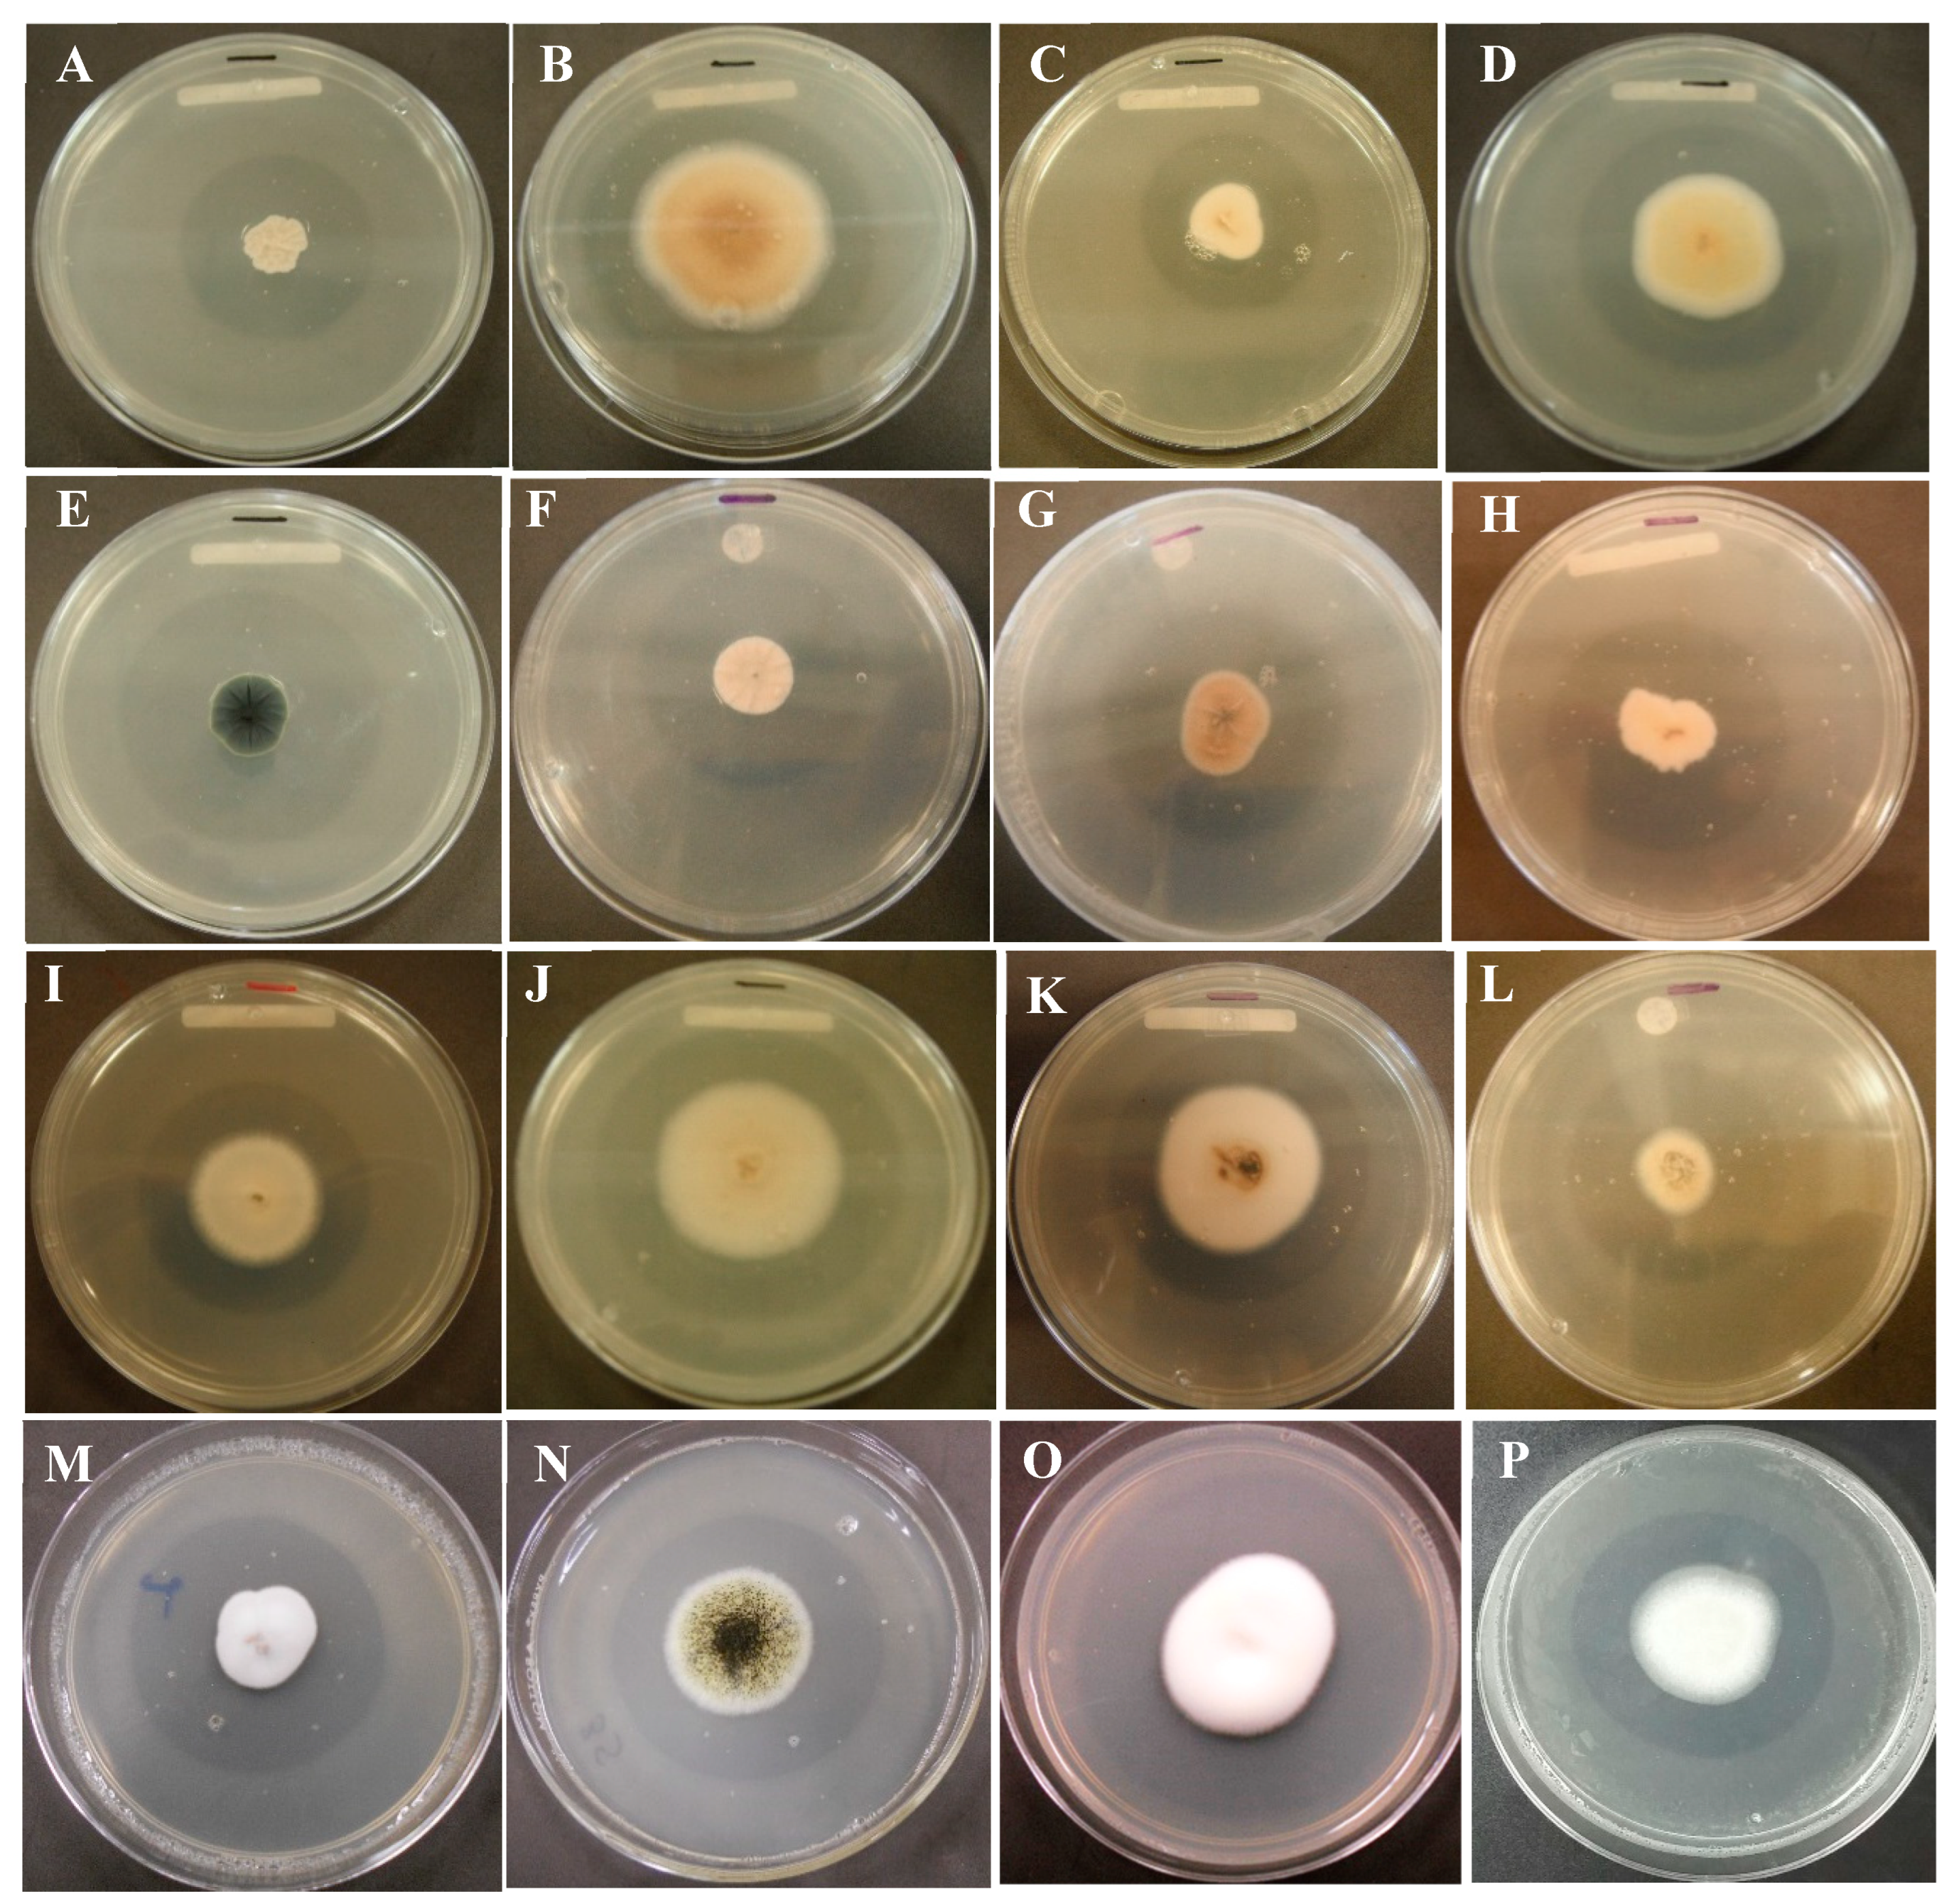

Submitted:
24 July 2023
Posted:
26 July 2023
You are already at the latest version
Abstract
Keywords:
1. Introduction
2. Results
2.1. Selection of strains with phosphate solubilizing capacity
2.2. Phosphate Solubilization and pH in Sundara
2.3. Acid phosphatases
2.4. Coffee plant foliar phosphorus
2.5. Soil phosphorus available to the coffee plants
2.6. Production of mature cherries in the coffee plants
3. Discussion
4. Materials and Methods
Determination of Solubilization Index
Phosphate Solubilization Efficiency of Fungal Isolates
Phosphatase activity assay
Characterization of isoenzymatic patterns
Inoculation of an PSF strain in coffee plants under field conditions
Variable measurement
Physico-chemical analysis of the soil
Statistical analysis of data
Author Contributions
Funding
Acknowledgments
Conflicts of Interest
References
- SAGARPA. Café, la bebida que despierta a México. Secretaría de Agricultura, Ganadería, Desarrollo Rural, Pesca y Alimentación: https://www.gob.mx/agricultura/articulos/cafe-la-bebida-que-despierta-a-mexico?idiom=es (Accessed 01/06/2023).
- SIAP. Avance De Siembras Y Cosechas Resumen Nacional Por Estado Otoño-Invierno Riego Temporal. Servicio de Información Agroalimentaria y Pesquera: http://www.cenacafe.org.mx/plataformas.html (Accessed 05/05/2023).
- Vandermeer, J.H. The coffee Agroecosystem in the Neotropics: Combining Ecological and Economic Goals. Trop. Subtrop. Agroecosystems. 2003, 159–194. [Google Scholar]
- Giovannucci, D.; Juárez, C.R. Análisis Prospectivo de Política Cafetalera. México, Proyecto Evaluación Alianza para el campo 2005. SAGARPA 2006.
- Moguel, Y.; Toledo, V. El café en México. Ecología, cultura indígena y sustentabilidad. Ciencias 1996, 43, 40–51. [Google Scholar]
- Arcila, J. Crecimiento y desarrollo de la planta de café. In Sistemas de producción de café en Colombia; Ospina, H. y Marín, S., Ed.; Cenicafe: Colombia, 2007; pp. 21–60. [Google Scholar]
- Geissert, D.; Ibañez, A. Calidad y ambiente fisicoquímico de los suelos. In Agroecosistemas cafetaleros del estado de Veracruz biodiversidad, manejo y conservación; Manson, R.H., Hernández, V., Gallina, O.S., Mehltreter, K. Eds. Instituto de Ecología, México 2008; pp. 15-44.
- Kour, D.; Rana, K.L.; Kaur, T.; Yadav, N.; Yadav, A.N.; Kumar, M.; Kumar, V.; Dhaliwal, H.S.; Saxena, A.K. Biodiversity, current developments and potential biotechnological applications of phosphorus solubilizing and mobilizing microbes: A review. Pedosphere 2021, 31, (1),43–75. [Google Scholar] [CrossRef]
- Navarro, G.; Navarro, S. En Química agrícola: el suelo y los elementos químicos esenciales para la vida vegetal, 2nd ed.; Ediciones Mundi Prensa; España, 2003.
- Yadav, B.K.; Verma, A. Phosphate solibilization and mobilization in soil through microorganisms under arid ecosystems. In The Functioning of Ecosystems; Ali, M., Ed.; The Functioning of Ecosystems. Croatia, 2012; pp. 99–108. [Google Scholar]
- Sharma, S.; Sayyed, R.; Trivedi, M.; Gobi, T. Review Phosphate solubilizing microbes: sustainable approach for managing phosphorus deficiency in agricultural soils. Springerplus 2013, 2, 587. [Google Scholar] [CrossRef] [PubMed]
- Beltrán, M. La solubilización de fosfatos como estrategia microbiana para promover el crecimiento vegetal. Cien. Tecnol. Agropecuaria 2014, 15, 101–113. [Google Scholar] [CrossRef]
- Arcand, M.M.; Schneider, K.D. Plant-and microbial-based mechanisms to improve the agronomic effectiveness of phosphate rock: a review. An. Acad. Bras. 2006, 78, 791–807. [Google Scholar] [CrossRef]
- Souza, R.D.; Ambrosini, A.; Passaglia, L.M. Plant growth-promoting bacteria as inoculants in agricultural soils. Genet. Mol. Biol. 2015, 38, 401–419. [Google Scholar] [CrossRef]
- Silva, G.N.; Vidor, C. Solubilização de fosfatos por microrganismos na presença de fontes de carbono. Rev. Bras. Cienc. Solo 2000, 24, 311–329. [Google Scholar] [CrossRef]
- Posada, R.H.; De Prager, M.S.; Sieverding, E.; Dorantes, K.A.; Heredia, G.P. Relaciones entre los hongos filamentosos y solubilizadores de fosfatos con algunas variables edáficas y el manejo de cafetales. Rev. Biol. Trop. 2012, 60, 1075–1096. [Google Scholar] [CrossRef]
- Arias, R.M; Juárez, A.; Heredia, G.; De la Cruz, Y. Capacidad fosfato solubilizadora de hongos rizosféricos provenientes de cafetales de Jilotepec, Veracruz. AyT BUAP 2022, 7(27), 69–86. [Google Scholar] [CrossRef]
- Vera, D.H.; Herando, P.; Herando, V. Aislamiento de hongos solibilizadores de fosfatos de la rizósfera de Arazá (Eugenia stipitata, Myrtaceae). Acta Biol. Colomb. 2002, 7, 33–4. [Google Scholar]
- Oliveros, A.; Macías, F.; Fernández, C.; Marín, D.; Molinillo, J. Exudados de la raíz y su relevancia actual en las interacciones alelopáticas. Quim. Nova 2009, 32, 198–213. [Google Scholar] [CrossRef]
- Ponmurugan, P.; Gopi, C. Distribution pattern and screening of phosphate solubilizing bacteria isolated from different food and forage crops. J. Agron. 2006, 5, 600–604. [Google Scholar] [CrossRef]
- Djuuna, A.; Prabawardani, S.; Massora, M. Population distribution of phosphate-solubilizing microorganisms in agricultural soil. Microbes Environ. 2022, 37. [Google Scholar] [CrossRef] [PubMed]
- Ceci, A.; Pinzari, F.; Russo, F.; Maggi, O.; Persiani, A. Saprotrophic soil fungi to improve phosphorus solubilisation and release: In vitro abilities of several species. Ambio 2018, 47, 30–40. [Google Scholar] [CrossRef]
- Nahidan, S.; Ahadi, N.; Abduolrahimi, S. Efficiency of some fungal species in phosphate solubilization and potassium and iron release from phlogopite and muscovite. Applied Soil Research 2023, 11, 112–124. [Google Scholar]
- Jyothi, V.; Basaiah, T. Isolation and Characterization of Phosphofungi–Aspergillus niger from Rhizosphere Soil to supplement Phospho-biofertilizer. Res. Sq. 2022. [Google Scholar] [CrossRef]
- Vyas, P.; Rahi, P.; Chauhan, A.; Gulati, A. Phosphate solubilization potencial ans stress tolerance of Eupenicillium parvum from tea soil. Mycol Res. 2007, 111, 931–938. [Google Scholar] [CrossRef]
- Krishna, P.; Sukla, L. Isolation of phosphate solubilizing fungus from rice fields of Odisha for agro-ecological sustainable agriculture. Environ. Qual. Manag. 2022, 32, 19–27. [Google Scholar] [CrossRef]
- Răut, I.; Călin, M.; Capră, L.; Gurban, A.; Doni, M.; Radu, N.; Jecu, L. Cladosporium sp. isolate as fungal plant growth promoting agent. Agron. 2021, 11. [Google Scholar] [CrossRef]
- Doilom, M.; Guo, J.; Phookamsak, R.; Mortimer, P.; Karunarathna, S.; Dong, W. , Liao, C.; Yan, K.; Pem, D.; Suwannarach, N.; Promputtha, I.; Lumyong, S.; Xu, J. Screening of phosphate-solubilizing fungi from air and soil in Yunnan, China: four novel species in Aspergillus, Gongronella, Penicillium, and Talaromyces. Front. Microbiol. 2020, 11, 585215. [Google Scholar] [CrossRef] [PubMed]
- Gupta, N.; Das, S.J. Phosphate solubilizing fungi from Mangroves of Bhitarkanika, Orissa. Hayati J. Biosci. 2008, 15, 90–92. [Google Scholar] [CrossRef]
- Sang, Y.; Jin, L.; Zhu, R.; Yu, X.; Hu, S.; Wang, B.; Ruan, H.; Jin, F.; Lee, H. Phosphorus-Solubilizing Capacity of Mortierella Species Isolated from Rhizosphere Soil of a Poplar Plantation. Microorganisms 2022, 10. [Google Scholar] [CrossRef] [PubMed]
- Islam, M.; Sano, A.; Hossain, M.; Sakagami, J. Isolation and molecular characterization of phosphate solubilizing filamentous fungi from subtropical soils in Okinawa. Appl. Ecol. Environ. Res. 2019, 17. [Google Scholar] [CrossRef]
- Yasser, M.; Mousa, A.; Massoud, O.; Nasr, S. Solubilization of inorganic phosphate by phosphate solubilizing fungi isolated from Egyptian Soils. J. Biol. Earth Sci. 2014, 4. [Google Scholar]
- Ahmad, A.; Moin, S.; Liaqat, I.; Saleem, S.; Muhammad, F.; Mujahid, T.; Zafar, U. Isolation, Solubilization of Inorganic Phosphate, and Production of Organic Acids by Individual and Co-inoculated Microorganisms. Geomicrobiol. J. 2022, 1–11. [Google Scholar] [CrossRef]
- Fenice, M.; Selbman, L.; Federici, F.; Vassilev, N. Application of encapsulated Penicillium variable P16 in solubilization of rock phosphate. Bioresour. Technol. 2000, 73, 157–162. [Google Scholar] [CrossRef]
- Pandey, A.; Das, N.; Kumar, B.; Rinu, K.; Trivedi, P. Phosphate solubilization by Penicillium spp. isolated from soil samples of Indian Himalayan region. World j. Microbiol. Biotechnol. 2008, 24, 97–102. [Google Scholar] [CrossRef]
- Morales, A.; Alvear. M.; Valenzuela, E.; Castillo, C.E.; Borie, F. Screening, evaluation and selection ofphosphate-solubilising fungi as potential biofertiliser. J. Soil Sci. Plant Nutr. 2011, 11, 89–103. [Google Scholar] [CrossRef]
- Rathore, P.; Phanse, N.; Patel, B. Screening for microorganisms possessing phosphate solubilizing potential. Indian J. Res. 2014, 3, 172–174. [Google Scholar] [CrossRef]
- Gizaw, B.; Tsegay, Z.; Tefera, G.; Aynalem, E.; Wassie, M.; Abatneh, E. Phosphate solubilizing fungi isolated and characterized from Teff rhizosphere soil collected from North Showa zone, Ethiopia. Afr. J. Microbiol. Res. 2017, 11, 687–696. [Google Scholar] [CrossRef]
- Wakelin, S.; Warren, R.; Harvey, P.; Ryder, M. Phosphate solubilization by Penicillium spp. closely associated with wheat roots. Biol. Fertil. Soils 2004, 40, 36–43. [Google Scholar] [CrossRef]
- Ñústez, C.E.; Acevedo, J.C. Evaluación del uso de Penicillium janthinellum Biourge sobre la eficiencia de la fertilización fosfórica en el cultivo de la papa (Solanum tuberosum L. var. Diacol Capiro). Agron. Colomb. 2005, 23, 290–298. [Google Scholar]
- Moreno, N.; Moreno, L.; Uribe, D. Biofertilizantes para la agricultura en Colombia. En Biofertilizantes en Iberoamérica: una visión técnica, científica y empresarial; Izaguirre-Mayoral, M.L., Labanderay, C., Sanjuán, J. Eds.; Editorial Universitaria: Cuba 2007; pp. 38-45.
- Morales, A.; Alvear, M.; Valenzuela, E.; Castillo, C.E.; Borie, F. Screening, evaluation and selection ofphosphate-solubilising fungi as potential biofertiliser. J. Soil Sci. Plant Nutr. 2011, 11, 89–103. [Google Scholar] [CrossRef]
- Elías, F.; Woyessa, D.; Muleta, D. Phosphate solubilization potential of Rhizosphere fungi isolated from plants in Jimma Zone, Southwest Ethiopia. Int. J. Microbiol. 2016. [Google Scholar] [CrossRef]
- Hernández, T.; Carrión, G.; Heredia, G. Solubilización in vitro de fosfatos por una cepa de Paecilomyces lilacinus (Thom) Samson. Agrociencia 2011, 45, 881–892. [Google Scholar]
- Verma, A.; Ekka, A. Isolation, screening and assessment of phosphate solubiling efficiency of some fungal isolates of Raipur, Chhattisgarh. IOSR J. Environ. Sci., Toxicol. Food Technol. 2015, 1, 29–39. [Google Scholar]
- Hajjam, Y.; Cherkaoui, S. The influence of phosphate solubilizing microorganisms on symbiotic nitrogen fixation: Perspectives for sustainable agriculture. J. Mater. Environ. Sci. 2017, 8, 801–808. [Google Scholar]
- Romero, J.; Arias, R.; Bañuelos, J.; De la Cruz, Y. (2019). Efecto de la inoculación de hongos solubilizadores de fósforo y micorrízicos arbusculares sobre el crecimiento de plantas de jitomate (Lycopersicon esculentum Mill). Rev. Mex. Cienc. Agri. 2019, 10, 1747–1757. [Google Scholar] [CrossRef]
- Saxena, J.; Saini, A.; Ravi, I.; Chandra, S.; Garg, V. Consortium of phosphate solubilizing bacteria and fungi for promotion of growth and yield of chickpea (Cicer arietinum). J. Crop Improv. 2015, 29, 353–369. [Google Scholar] [CrossRef]
- Moreno, A.; Osorio, N.; González, O. In vitro dissolution of acidulated rock phosphate by phosphate solubilizing microorganisms. Acta Biol. Colomb. 2015, 20, 65–71. [Google Scholar] [CrossRef]
- Lima-Rivera, D.; López-Lima, D.; Desgarennes, D.; Velázquez-Rodríguez, A.; Carrión, G. Phosphate solubilization by fungi with nematicidal potential. J. Soil Sci. Plant Nutr. 2016, 16, 507–524. [Google Scholar] [CrossRef]
- Selvi, K.; Paul, J.; Vijaya, V.; Saraswathi, K. Analyzing the Efficacy of Phosphate Solubilizing Microorganisms. Enrichment Culture Techniques. Biochem. Mol. Biol. 2017, 3, 7–1. [Google Scholar] [CrossRef]
- Illmer, P.; Barbato, A.; Schinner, F. Solubilization of hardly-soluble AlPO4 with P-solubilizing microorganisms. Soil Biol. Biochem. 1995, 27, 265–270. [Google Scholar] [CrossRef]
- Whitelaw, M.; Harden, T.; Helyar, K. Phosphate solubilization in solution culture by the soil fungus Penicillium radicum. Soil biol. Biochem. 1999, 31, 655–665. [Google Scholar] [CrossRef]
- Nasr, S.; Mousa, A.; Marzouk, M.; Yasser, M. Quantitative and Qualitative Analysis of Organic Acids Produced by Phosphate Solubilizing Fungi. Egypt. J. Bot. 2021, 61, 167–176. [Google Scholar] [CrossRef]
- Richa, G.; Khosla, B.; Reddy, M.S. Improvement of maize plant growth by phosphate solubilizing fungi in rock phosphate amended soils. World J. Agric. Sci. 2007, 3, 481–484. [Google Scholar]
- Rodríguez, H.; Gonzalez, T.; Goire, I.; Bashan, Y. Gluconic acid production and phosphate solubilization by the plant growth-promoting bacterium Azospirillum spp. Naturwissenschaften 2004, 91, 552–555. [Google Scholar] [CrossRef]
- Gyaneshwar, P.; Naresh, G.; Parekh, L.; Poole, P. Role of soil microorganisms in improving P nutrition of plants. Plant and soil 2002, 245, 83–93. [Google Scholar] [CrossRef]
- Gómez, Y.; Zabala, M. Determinación de la capacidad solubilizadora del P en hongos aislados de la rizósfera del mani (Arachis hypogaea L.). Saber Universidad de Oriente 2001, 13, 8–13. [Google Scholar]
- Chung-Chao, C.; Yu-Lin, K.; Chen-Ching, C.; Wei-Liang, C. Solubilization of inorganic phosphates and plant growth promotion by Aspergillus niger. Biol. Fertil. Soils 2007, 43, 575–584. [Google Scholar] [CrossRef]
- Vitorino, L.C.; Silva, F.G.; Soares, M.A.; Souchie, E.L.; Costa, A.C.; Lima, W.C. Solubilization of calcium and iron phosphate and in vitro production of Indoleacetic acid by Endophytic isolates of Hyptis marrubioides Epling (Lamiaceae). Int. Res. J. Biotechnol. 2012, 3, 47–54. [Google Scholar]
- Narsian, V.; Patel, H.H. Aspergillus aculeatus as a rock phosphate solubilizer. Soil Biol. Biochem. 2000, 32, 559–565. [Google Scholar] [CrossRef]
- Reddy, M.S.; Kumar, S.; Babita, K.; Reddy, M.S. Biosolubilization of poorly soluble rock phosphates by Aspergiullus tubigensis and Aspergillus niger. Bioresour. Technol. 2002, 84, 187–189. [Google Scholar] [CrossRef] [PubMed]
- Barroso, C.B.; Nahas, E. The status of soil phosphate fractions and the ability of fungi to dissolve hardly soluble phosphates. Appl. Soil Ecol. 2005, 29, 73–83. [Google Scholar] [CrossRef]
- Sayer, J.A.; Raggett, S.L.; Gadd, G.M. Solubilization of insoluble metal compounds by soil fungi: development of a screening method for solubilizing ability and metal tolerance. Mycol. Res. 1995, 99, 987–993. [Google Scholar] [CrossRef]
- Anand, K.; Kumari, B.; Mallick, M. Phosphate solubilizing microbes: an effective and alternative approach as biofertilizers. Int. J. Pharm. Sci. 2016, 8, 37–40. [Google Scholar]
- Gómez, Y. Actividad de las fosfatasas ácidas y alcalinas (extracelulares e intracelulares) en hongos de la rizosfera de Arachis hypogaea (Papiloneaceae). Rev. Biol. Trop. 2004, 52, 287–295. [Google Scholar] [CrossRef]
- Valenzuela, E.; Toro, V.; Martínez, O.; Pinochet, D. Determinación de fosfatasas en hongos de praderas. Bol. Micol. 2005, 20. [Google Scholar] [CrossRef]
- Huang, Y.; Zhang, L.; Yuan, S.; Liu, W.; Zhang, C.; Tian, D.; Ye, X. The Production of Oxalate by Aspergillus niger under Different Lead Concentrations. Agronomy 2023, 13. [Google Scholar] [CrossRef]
- Perea, Y.; Arias, R.; Medel, R.; Trejo, D.; Heredia, G.; Rodríguez, Y. Effects of native arbuscular mycorrhizal and phosphate-solubilizing fungi on coffee plants. Agrofor. Syst. 2018, 93, 961–972. [Google Scholar] [CrossRef]
- Chakraborty, B.; Chakraborty, U.; Saha, A.; Sunar, K.; Dey, P. Evaluation of phosphate solubilizers from soils of North Bengal and their diversity analysis. World J. Agric. Sci. 2010, 6, 195–200. [Google Scholar]
- Patiño, C.O.; Sanclemente, O.E. Los microorganismos solubilizadores de fósforo (MSF): una alternativa biotecnológica para una agricultura sostenible. Entramado 2014, 10, 288–297. [Google Scholar]
- Sashidhar, B.; Podile, A.R. Mineral phosphate solubilization by rhizosphere bacteria and scope for manipulation of the direct oxidation pathway involving glucose dehydrogenase. J. Appl. Microbiol. 2010, 109, 1–12. [Google Scholar] [CrossRef] [PubMed]
- Emami-Karvani, Z.; Chitsaz-Esfahani, Z. Phosphorus Solubilization: Mechanisms, Recent Advancement and Future Challenge. In: Yadav, A. Eds. Soil Microbiomes for Sustainable Agriculture. Sustainable Development and Biodiversity, 2021, vol 27, pp. 85-131. [CrossRef]
- Vassileva, M.; Mocali, S.; Canfora, L.; Malusá, E.; García del Moral, L.; Martos, V.; Peregrin, E.; Vassilev, N. Safety level of microorganism-bearing products applied in soil-plant systems. Front. Plant Sci. 2022, 13, 862875. [Google Scholar] [CrossRef] [PubMed]
- Edi-Premono, M.; Moawad, A.; Vleck, L.G. Effect of phosphate-solubilizing Pseudomonas putida on the growth of maize and its survival in the rhizosphere. Indones. J. Crop Sci. 1996, 11, 13. [Google Scholar] [CrossRef]
- Sundara, V.B.; Sinha, M.K. Phosphate dissolving organisms in the soil and rizosphere. Indian j. Sci. 1963, 33, 272–278. [Google Scholar]
- Clesceri, S.; Greenberg, A.; Trusell, R. En Métodos normalizados para el análisis de aguas potables y residuales, 17th ed.; Díaz Santos Ed; España 1992; pp. 4201-4202.
- Tabatabai, M.A.; Bremner, J.M. Use of p-nitrophenyl phosphate for assay of soil phosphatase activity. Soil Biol. Biochem. 1969, 1, 301–307. [Google Scholar] [CrossRef]
- Senasica. Manual Técnico Operativo. Centro Nacional de Referencia Fitosanitaria, Área de Vigilancia Epidemiológica Fitosanitaria. Servicio Nacional de Sanidad, Inocuidad y Calidad Agroalimentaria: https://prod.senasica.gob.mx/SIRVEF/ContenidoPublico/Accion%20operativa/Manual%20operativo/Manual%20operativo%20VEF%202019.pdf (Accessed 01/05/2021).
- McKean, S.J. Manual de análisis de suelos y tejido vegetal: Una guía teórica y práctica de metodologías. CIAT 1993, (129), 1–99. [Google Scholar]
- Bray, R.H.; Kurtz, L.T. Determination of total, organic and available forms of phosphorus in soil. Soil Sci. 1945, 59, 39–45. [Google Scholar] [CrossRef]
- StatSoft Inc. Statistica to Windows v.7.0. Data analysis software system. Tulsa 2007. 2007.

| Fungal strain | Solubilization index | ||||||||
| Aspergillus niger | 2.60 | 1.91 | 1.90 | ||||||
| Acremonium roseolum | 1.72 | 2.34 | 2.44 | 2.43 | 2.46 | 2.54 | 2.47 | 2.45 | |
| Aspergillus candidus | 2.35 | 2.64 | 2.53 | 2.95 | 2.97 | 2.88 | 2.88 | 2.00 | |
| Aspergillus sclerotiorum | 2.44 | 1.20 | 1.30 | 1.36 | 1.48 | 1.50 | 1.48 | 1.41 | |
| Aspergillus sydowii | 1.80 | 1.75 | 1.66 | 1.63 | 1.59 | 1.39 | 1.32 | 1.14 | |
| Aspergillus sp. 1Y | 1.37 | 1.43 | 1.61 | 1.69 | 1.81 | 1.77 | 1.70 | 1.62 | |
| Cladosporium cladosporioides | 1.59 | 2.27 | 2.72 | 2.61 | 2.60 | 2.58 | 2.36 | 2.54 | |
| Epicoccum nigrum | 1.87 | 2.22 | 2.12 | 2.03 | 1.97 | 1.82 | 1.74 | 1.59 | |
| Eupenicillium euglaucum | 2.00 | 2.39 | 2.51 | 2.58 | 2.73 | 2.82 | 2.82 | 2.86 | |
| Eupenicillium ludwigii | 3.53 | 3.08 | 2.61 | 2.64 | 2.65 | 2.65 | 3.05 | 2.91 | |
| Fusarium sp. C25 | 2.80 | 2.76 | 2.68 | 2.67 | 2.67 | 2.48 | 2.34 | 2.19 | |
| Fusarium sp. 3Y | 2.50 | 2.42 | 2.44 | 2.34 | 2.27 | 2.05 | 1.96 | ||
| Humicola sp. 2gh205 | 2.14 | 2.01 | 1.79 | 1.76 | 1.72 | 1.69 | 1.72 | 1.55 | |
| Merimbla sp. 3gh18 | 1.76 | 1.75 | 1.76 | 1.72 | 1.63 | 1.59 | 1.54 | 1.77 | |
| Penicillium arenicola | 1.42 | 1.74 | 1.77 | 2.02 | 1.68 | 1.63 | 1.41 | 1.31 | |
| Penicillium brevicompactum | 2.47 | 2.96 | 3.37 | 3.61 | 3.36 | 3.11 | 2.94 | 2.64 | |
| Penicillium glabrum | 1.47 | 1.70 | 1.72 | 1.62 | 1.64 | 1.53 | 1.39 | 1.35 | |
| Penicillium miczynskii | 2.26 | 2.09 | 1.94 | 2.17 | 2.70 | 1.96 | 1.97 | 1.72 | |
| Penicillium olsonii | 1.82 | 1.98 | 2.00 | 1.93 | 1.87 | 1.77 | 1.68 | 1.67 | |
| Penicillium verrucosum | 1.43 | 1.93 | 1.99 | 2.07 | 1.86 | 1.61 | 1.47 | 1.34 | |
| Penicillium waksmanii | 1.76 | 2.80 | 3.20 | 3.60 | 3.67 | 3.88 | 3.83 | 3.79 | |
| Penicillium sp. 90 | 2.13 | 2.20 | 2.12 | 2.16 | 2.05 | 2.12 | 2.05 | 1.85 | |
| Sagenomella diversispora | 2.83 | 2.93 | 3.23 | 3.10 | 3.15 | 2.95 | 2.83 | 2.63 | |
| Scopulariopsis brevicaulis | 1.98 | 2.77 | 2.95 | 2.76 | 2.61 | 2.66 | 2.30 | 2.16 | |
| Talaromyces flavus var. flavus | 3.52 | 2.66 | 2.02 | 2.00 | 2.12 | 2.14 | 2.30 | 2.21 | |
| Trichocladium asperum | 2.43 | 2.87 | 2.85 | 3.00 | 3.34 | 3.15 | 3.33 | 3.00 | |
| Sites | Annual mean precipitation | Latitude | Longitude | Elevation (masl) | Mean temperature | Management type | Soil type |
|---|---|---|---|---|---|---|---|
| San Isidro | 241 | 19°36’42.74’’ | 96°56’16.01’’ | 1370 | 22 | Traditional polyculture | Andosol |
| Los Bambús | 275.9 | 19°36’38.07’’ | 96°55’40.57’’ | 1414 | 25 | Traditional polyculture | Andosol |
| La Barranca | 298.2 | 19°36’12.15’’ | 96°54’44.91’’ | 1484 | 25 | Traditional polyculture | Andosol |
| Coffee plantations | |||
|---|---|---|---|
| “San Isidro” | “Los Bambus” | “La Barranca” | |
| pH | 6.11 | 6.69 | 5.43 |
| Retained P | 87.35 | 89.8 | 81.63 |
| Organic material | 12.46 | 3.93 | 4.72 |
| Organic carbon | 7.23 | 2.28 | 2.74 |
| Cation exchange capacity (CEC) | 27.09 | 20.88 | 21.51 |
| field capacity (FC) | 31.72 | 22.69 | 21.62 |
| Bulk density | 0.893 | 1.016 | 0.994 |
| Clay | 29.8 | 45.8 | 49.8 |
| Silt | 30.56 | 22.56 | 28.56 |
| Sand | 39.64 | 31.64 | 21.64 |
| Texture | Clay loam | Clay | Clay |
| Fe | 69.38 | 111.63 | 163.03 |
| C | 8.5 | 2.9 | 3.5 |
| N | 0.72 | 0.27 | 0.27 |
Disclaimer/Publisher’s Note: The statements, opinions and data contained in all publications are solely those of the individual author(s) and contributor(s) and not of MDPI and/or the editor(s). MDPI and/or the editor(s) disclaim responsibility for any injury to people or property resulting from any ideas, methods, instructions or products referred to in the content. |
© 2023 by the authors. Licensee MDPI, Basel, Switzerland. This article is an open access article distributed under the terms and conditions of the Creative Commons Attribution (CC BY) license (http://creativecommons.org/licenses/by/4.0/).